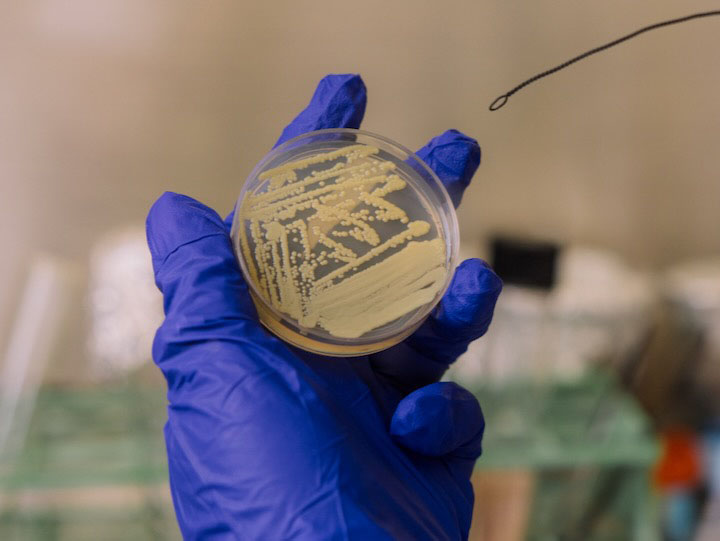

A rare microorganism found in an unexpected environment may be evading detection by “playing dead,” according to microbiologists at the University of Houston.

Discovered in NASA spacecraft assembly clean rooms, this rare novel bacterium, called Tersicoccus phoenicis (T. phoenicis), could have major implications for planetary protection and clean room sterilization practices, said Madhan Tirumalai, lead author of this study published in August in Microbiology Spectrum, a peer-reviewed scientific journal from the American Society for Microbiology.
Originally discovered over a decade ago in two clean rooms in Florida and French Guiana, T. phoenicis surprised scientists, as these facilities are rigorously cleaned to prevent microbial contamination of spacecraft and, potentially, other planets.
Tirumalai, a research assistant professor in UH’s Department of Biology and Biochemistry, collaborated with others from the department — Professor William Widger, graduate student Sahar Ali and Emeritus Professor George E. Fox — to investigate how T. phoenicis survived in the harsh environment.
Their research revealed the bacterium could possibly evade detection by entering dormancy, a state of extremely low metabolic activity where it stops growing.
“These clean rooms are extreme habitats for microbial adaptation and evolution,” Tirumalai said. “These findings highlight the resilience of spacecraft-associated microbes, and it has a huge planetary protection concern.”
The Path to Discovery
T. phoenicis is a non-spore-forming strain member of actinobacteria. While little was previously known about this specific strain, other actinobacteria — such as the bacterium that causes tuberculosis, namely Mycobacterium tuberculosis — are known to enter dormancy when they run out of nutrition.
Dormancy is a key survival strategy for actinobacteria, allowing them to resist antibiotics and remain inactive until conditions improve.
The UH team knew a related actinobacteria, Micrococcus luteus (M. luteus), can be revived from dormancy by using a resuscitation-promoting factor — a common protein found in actinobacteria. Because M. luteus and T. phoenicis share genetic features, the researchers tested how T. phoenicis responded to the protein.
The research group of Widger’s, of which Ali is a part of, already had the necessary
ingredients to carry out the test.
When they added the protein, T. phoenicis cells “woke up,” confirming the bacterium
can “play dead” to survive nutrient starvation and possibly resist the stringent conditions
in spacecraft clean rooms, Widger said.



What’s Next?
Beyond spacecraft assembly facilities, dormant actinobacteria may be hiding in other sterile environments, such as hospitals, pharmaceutical labs and food processing facilities. As research into microbial survival in extreme environments advances, Tirumalai said he hopes it will lead to better detection methods and more effective sterilization strategies.

“I think other industries are missing the idea that these bacteria can evade detection in their clean rooms by going dormant,” Widger said. “We don't know if they're going to be nasty bacteria — they may not be — but it would be nice to know if they're there or not.”
UH researchers’ findings could also contribute to further control of pathogenic bacteria like the one that causes tuberculosis. If scientists can prevent these bacteria from entering dormancy, they may become easier to eliminate with antibiotics or sterilization techniques.
“If we can find a way to prevent the bacteria from going latent, maybe the antibiotics could kill it before it goes into dormancy,” Widger said.